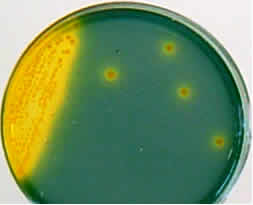

Vibrio parahaemolyticus çubuk şeklinde, gram negatif, hareketli bir mikroorganizmadır. Optimum üreme sıcaklığı 35-37°C arasındadır. Vibrio parahaemolyticus esas olarak sahil ve nehir ağızlarında bulunan bir mikroorganizmadır, açık denizlerden yakalanan balıklarda ender olarak bulunur.
Özellikle balık, istiridye, karides ve yengeç gibi su ürünleri ve sular bu bakteri açısından yüksek risk grubundaki gıdalardır. Dondurulmuş gıdalarda da canlılığını sürdürebilir. Enfeksiyon insanlarda kusma ve ishale neden olur. Belirtiler bu bakteriyi barındıran kabuklu deniz ürünlerinin çiğ ya da az pişmiş olarak yenilmesinden yaklaşık 24 saat sonra başlar.
Vibrio parahaemolyticus Analizi
3-4 iş günü
500 g / 500 ml
Mikrobiyolojik
Bu analiz TURKAK tarafından TS EN ISO/IEC 17025 standardına göre akredite edilmiştir. ISO 21872-1:2007 standardına göre çalışılmaktadır.
-
0,00TL
- KDV Dahildir



-228x228.jpg)




